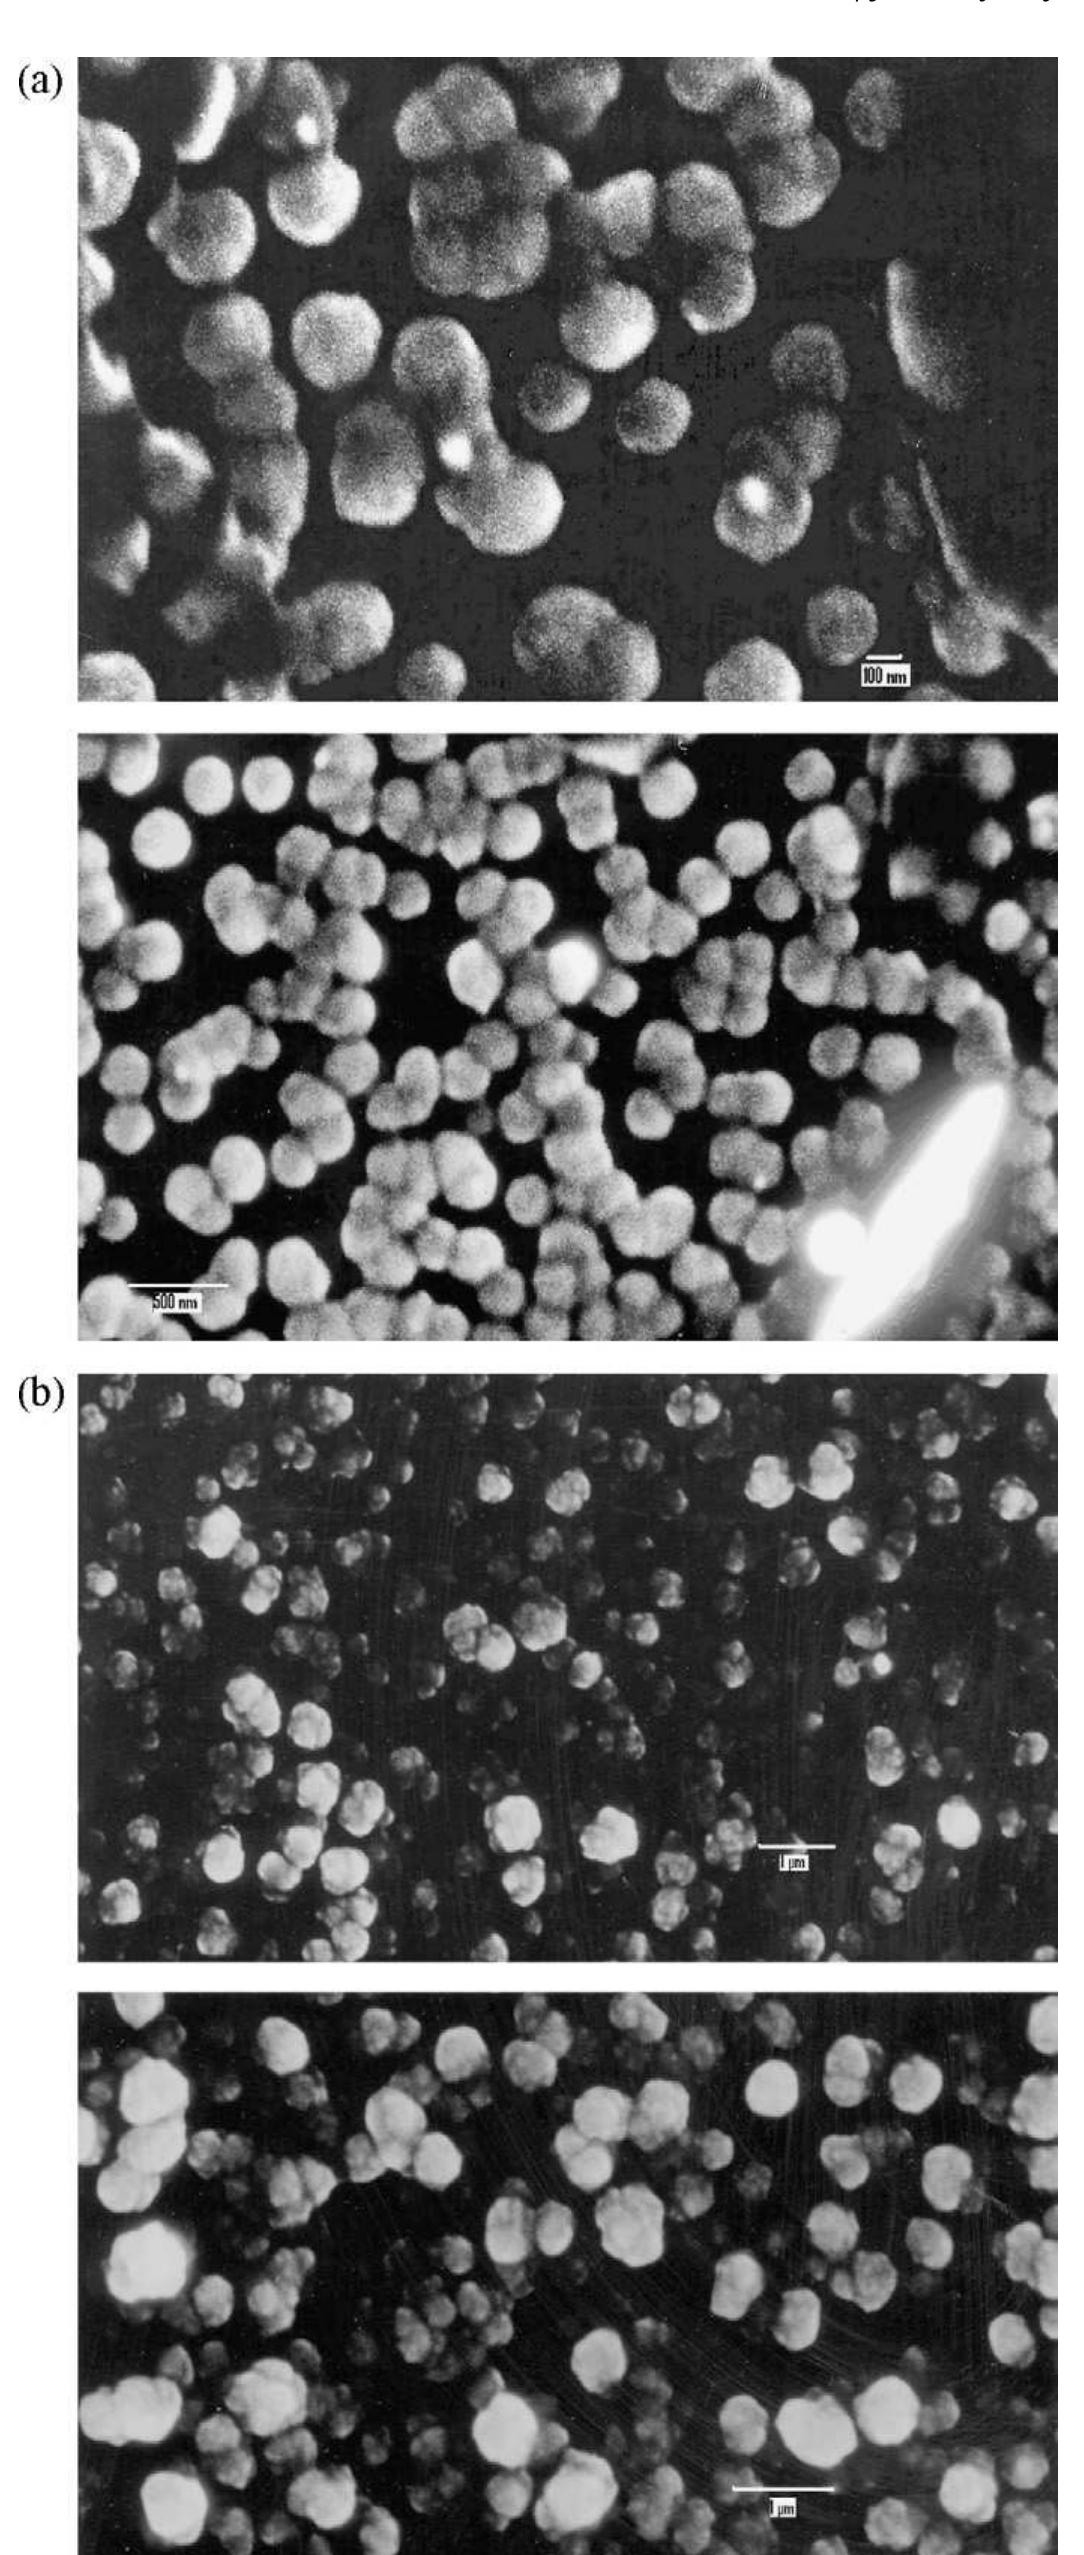

The most original and shocking interpretation of Lucretius in the last 40 years. Thomas Nail argues convincingly and systematically that Lucretius was not an atomist, but a thinker of kinetic flux. In doing so, he completely overthrows... more
A charged photon and its light-speed helical trajectory form a surprising new solution to the relativistic electron’s energy-momentum equation. This charged photon model is a new model for the electron, and quantitatively resembles the... more
This research was funded by, and implemented within, a UK national research organisation, while the author was the KE and Impact Evaluation Manager responsible for assessing impact on a £15m UK government-funded research programme. This... more
A superluminal quantum-vortex model of the electron and the positron is produced from a superluminal double-helix model of the photon during electron-positron pair production. The two oppositely-charged (with Q = ±e sqrt (2/α) = 16.6e)... more
Abstract Using XPS and x-ray-excited Auger electron spectroscopy (XAES), we have studied the variation in surface composition of CuO and Cu 2 O with a variety of high-vacuum treatments, including vacuum annealing, oxidation and hydrogen... more
Time is consciousness ( Time mindness or Atomic genes , TM ) present in CCP ( thought script of Anti mind particles ) While Space is Void which is Nothing . How could space create ripples ? A Fake Mathematical Theory of Space Time... more
Consolidated tables showing an extensive listing of the highest independently confirmed efficiencies for solar cells and modules are presented. Guidelines for inclusion of results into these tables are outlined and new entries since... more
We review the various ways in which an electron beam can adversely affect an organic or inorganic sample during examination in an electron microscope. The effects considered are: heating, electrostatic charging, ionization damage... more
Solid oxide fuel cell (SOFC) technology has been under development for a broad range of power generation applications. The attractiveness of this technology is its efficient and clean production of electricity from a variety of fuels. The... more
Green synthesized copper oxide (CuO) nanoparticles (NPs) were employed as electrocatalytic materials for the fabrication of counter electrode in dye sensitized solar cells (DSSCs). Uniform CuO NPs were synthesized by the leaves extract of... more
Published online zzz PACS 78.55.Et, 78.67.Bf, 78.30.Fs
Abstract. We show that Friedel oscillations of the electron density exist in junctions between quasi-one-dimensional and two-dimensional systems. The backscattering of electrons by the Friedel oscillations can qualitatively explain a... more
Inorganic polymers based on alumina and silica polysialate units were synthesised from dehydroxylated aluminosilicate clay (metakaolinite) condensed with sodium silicate in a highly alkaline environment. Reaction of the aluminosilicate... more
Over the past 5 years, there has been a significant interest in employing terahertz (THz) technology, spectroscopy and imaging for security applications. There are three prime motivations for this interest: (a) THz radiation can detect... more
- The Solar Planets order proves that, the planet orbital distance is defined based on his Diameter and NOT his Mass, which disproves the Gravity Theory.. But - Planet Diameter and Orbital Distance Relationship Equation is so hard to... more
If commercialized, LENRs could become one of the world’s preeminent energy technologies. At system electrical power outputs of just 5 - 10 kwh, modular LENR-based distributed power generation systems providing combined heat and... more
This article continues to develop the charged-photon model of the electron. In particular, the relativistic de Broglie wavelength of a moving electron is derived from the model. De Broglie’s own derivation is also summarized and compared... more
Several Mediterranean countries are suffering from water scarcity, unsustainable management of water resources, vulnerability to climate change, pollution and lack of sanitation infrastructure and suitable treatment technologies. These... more
An overview of the mechanics of MerKaBa with direct reference to the author’s space-time theory/model of nested spherical dimensions of cosmos is presented. It is emphasized that the spherical dimensional edifice of cosmos may be... more
The laboratory uses methods and equipment developed at the Physics Department. They are subject to three Bulgarian inventions, and one Canadian patent of our laboratory’s team. Some of the devices developed, and used by the laboratory... more
This Impact Report identifies and summarises the diverse impacts, resulting from the £500m of UK funding of Science and Technology in 2013, using numerous quantitative metrics and short case study extracts. It shows how the varied... more
The thermoelectric properties of graphene and graphene nanostructures have recently attracted significant attention from the physics and engineering communities. In fundamental physics, the analysis of Seebeck and Nernst effects is very... more
A superluminal quantum-vortex model of the electron and the positron is produced from a superluminal double-helix model of the photon during electron-positron pair production. The two oppositely-charged (with Q = ±e sqrt(2/α) = 16.6e)... more
The program system MOLCAS is a package for calculations of electronic and structural properties of molecular systems in gas, liquid, or solid phase. It contains a number of modern quantum chemical methods for studies of the electronic... more
The study of Bose–Einstein condensation in dilute gases draws on many different sub fields of physics. Atomic physics provides the basic methods for creating and manipulating these systems, and the physical data required to characterize... more
Advances in low power design open the possibility to harvest ambient energies to power directly the electronics or recharge a secondary battery. The key parameter of an energy harvesting (EH) device is its efficiency, which strongly... more
QUANTUM ESPRESSO is an integrated suite of computer codes for electronic-structure calculations and materials modeling, based on density-functional theory, plane waves, and pseudopotentials (norm-conserving, ultrasoft, and... more
The strong coupling of light and excitons in a two-dimensional semiconductor microcavity results in a new eigenstate of quasiparticles called polaritons. Microcavity polaritons have generated much interest due to the wealth of interesting... more
This article outlines state-of-the-art energy technologies, including production and storage, available to us through semiconductor nanomaterials. The nanostructure growth processes have been illustrated in detail, with emphasis on the... more
The present investigation reports, the novel synthesis of nanoparticles Ni and NiO using thermal decomposition and their physicochemical characterization. The nanoparticles Ni powder have been prepared using... more
Interaction of solid state qubits with environmental degrees of freedom strongly affects the qubit dynamics, and leads to decoherence. In quantum information processing with solid state qubits, decoherence significantly limits the... more
The Earth moves with C velocity (light velocity) relative to the Sun i.e. The light is produced by The Earth Motion, where The Earth transforms her motion mechanical waves into light waves, producing the light beams These light... more
Einstein got ZERO Marks on the assumption of Space Time Gravity Theory calling Space time ripples on 6 June 1907. . But Noble Prize has been given on same illusive theory in 1993 and 2017. Pl read papers published condemning his theory of... more
THE MALE GOD PARTICLE THAT MAKES EVERYTHING THAT YOU SEE. AND, AS EVERYBODY KNOWS, MALES ARE A PROBLEM.
It is known that for certain metals with magnetic impurities, the resistivity decreases as temperature decreases but then reaches a minimum and after that it increases as − ln T as the temperature decreases further. Moreover, the... more
The principal techniques used in the physical characterization of thin-film solar cells and materials are reviewed, these being scanning probe microscopy (SPM), X-ray diffraction (XRD), spectroscopic ellipsometry, transmission electron... more
Rare-earth permanent magnets are ideally suited to generate magnetic fields comparable to their spontaneous polarization J S : Near-square hysteresis loops and large values of the coercivity and anisotropy fields greatly simplify magnet... more
This article attempts to give an overview of the literature on the treatment of textiles with non-thermal plasmas. Because of the enormous amount of potential uses of non-thermal plasmas for the modification of textile products,... more
Titanium oxide nanotubes were fabricated by anodic oxidation of a pure titanium sheet in an aqueous solution containing 0.5 to 3.5 wt% hydrofluoric acid. These tubes are well aligned and organized into high-density uniform arrays. While... more
Carbon supported PtRu alloys were prepared by impregnation of Pt and Ru precursors on a porous carbon support, followed by reduction of the metals with Na S O . After reduction, the samples were thermal treated in argon up to 7008C. The... more
This article shows how the charged photon model of the electron is consistent with the time-dependent and the time-independent forms of the one-dimensional Schrödinger equation, which describes the conservation of total energy of a... more
During the last two decades, the industry (including scientists) has focused on diamond-like carbon (DLC) coating because of its wide range of application in various fields. This material has numerous applications in mechanical,... more
Why there's No velocity higher than Light Velocity C =300000 km/sec? Because • The Matter is created from light beams coherence (according to Young Experiment-The Main Hypothesis) • The Time is created as the Matter Changing measurement •... more


























![Figure 10. The Cu LMM XAES spectra of Cu,0 reduced in 5 x 10-5 mbar H, at 420 K for 10 min and subsequently vacuum annealed. shown in Fig. 8(a) (i). Hydrogen treatment of the fully oxidized CuO at 400 K in 1 x 10°* Torr H, resulted in more extensive reduction with a further reduction in the Cu 2p satellite intensity [Fig. 8(a) (iii)]. Evidence for Cu metal can be seen from the lower binding energy shoul- der at 568.3 eV on the Cu LMM peak in Fig. 8(b) (iii). The fully oxidized CuO surface could be regenerated by vacuum annealing to 773 K for several minutes.](https://figures.academia-assets.com/45412025/figure_010.jpg)



![Figure 3. Measured values of dark conductivity o and of activation energy E,.; of dark conductivity for juc-Si:H layers, produced by PECVD, on glass: as a function of boron content in the deposited layers, as measured by Secondary Ion Mass Spectroscopy (SIMS).!° Boron-free layers are here n-type, because of unintentional doping by oxygen, as shown later. The compensation point is obtained at a doping phase ratio [B2H6]/[SiH,] of about 1 ppm, corresponding to a boron concentration (SIMS) of about 3 x 10!° at/em?. No correction for the statistical shift has been effected here (in contrast with Ficure 1), as the defect densities near the bandedges are assumed to be negligibly small for uc-Si:H layers](https://figures.academia-assets.com/45500040/figure_003.jpg)





















![Figure 1. (a) Normalized external quantum efficiency (EQE) of three of the new non-concentrator cell entries in this issue plus the Solarmer ‘notable exception’ cell from the previous version [3]; (b) Normalized EQE of four of the new non-concentrator cell entries in this issue plus the 25% efficient Si cell from Table |; (c) Normalized EQE of two of the new concentrator cell entries together of that of the record 41.6% device reported in the previous version [3].](https://figures.academia-assets.com/43206258/figure_001.jpg)
![* CIGS = CulnGaSe;; a-Si = amorphous silicon/hydrogen alloy. » Effic. = efficiency. “(ap) = aperture area; (t) = total area; (da) = designated illumination area. “FF = fill factor. °FhG-ISE = Fraunhofer Institut fiir Solare Energiesysteme; JQA = Japan Quality Assurance; AIST = Japanese National - Advanced Industrial Science and Technology. ‘Recalibrated from original measurement. ® Reported on a ‘per cell’ basis. * Not measured at an external laboratory. ‘Light soaked at Oerliken prior to testing at NREL (1000h, 1 sun, 50°C). )Measured under IEC 60904-3 Ed. 1: 1989 reference spectrum. ‘Stability not investigated. References [28] and [29] review the stability of similar devices. ‘Stabilized by 174h, 1 sun illumination after 20h, 5 sun illumination at a sample temperature of 50°C. Table I. Confirmed terrestrial cell and submodule efficiencies measured under the global AM1.5 spectrum (1000 W/m?) at 25°C (IEC 60904-3: 2008, ASTM G-173-03 global).](https://figures.academia-assets.com/43206258/table_001.jpg)

![* CIGS = CulnGaSep. » Effic. = efficiency. “(ap)= aperture area; (t) = total area; (da) = designated illumination area. “Recalibrated from original measurement. ®Light soaked under 100 mW/cm? white light at 50°C for 1000h. ‘Stability not investigated. References [28] and [29] review the stability of similar devices. 5 Light soaked under simulated AM1.5 for about 140h prior to shipment to NREL. Table Ill. ‘Notable Exceptions’: ‘Top ten’ confirmed cell and module results, not class records measured under the global AM1.5 spectrum (1000 W/m?) at 25°C (IEC 60904-3: 2008, ASTM G-173-03 global).](https://figures.academia-assets.com/43206258/table_003.jpg)














![where K is a constant, « is the absorption coefficient, Epnoton the dis- crete photo-energy, and E, the band gap energy. From this equation, the E, of biosynthesized CuO NPs is calculated to be ~1.86 eV, which is quite high as compared to bulk CuO and similar to reported CuO nanomaterials [32]. This increment in E, value is resulted from the formation of nanostructures in biosynthesis.](https://figures.academia-assets.com/44375757/figure_002.jpg)

![Fig. 5. J-V curve of DSSC fabricated with counter electrode based on synthesized CuO NPs from leaf of Calotropis gigantea. The reactions (1) and (2) are represented the reduction peak of I3/I- and oxidation peak of Ip/Iz3 in the CV plot [36]. In this case, a reasonably good cathodic current of 0.98 mA/cm? at ~—0.40V is obtained in the electrochemical system based on the synthesized CuO NPs counter electrode, indicating the high electrocatalytic activity toward the reduction of Iz to I” ions in the redox electro-](https://figures.academia-assets.com/44375757/figure_004.jpg)




![Fig. 3. Liquid-state “°Si NMR spectra of polymer mixtures recorded at the indicated elapsed times (minutes) after mixing: (A) Na-PSS1; (B) Na-PSS (C) Na-PSS7. In an attempt to determine the critical differences between good and poorly curing compositions, liquid-state MR was carried out on mixtures Na-PSS1, Na-PSS2 (with the same oxide molecular ratio as Na-PSS1 but higher water content and did not set) and Na-PSS7 (higher a content and poorer mechanical properties). The *°Si MR liquid spectrum of the initial sodium silicate [Fig. 2(A)] shows the sharp peaks of the Q°, Q', Q? and Q? sites at about —72, —80, —87 and —96 ppm, respectively [17], The Krebs- Stormer viscometer used here is of the shear type in which the rotational motion is applied using a paddle wheel rather than concentric cylinders. Although it is normally used for commercial process control, providing viscosity values expressed in arbitrary units, it may be calibrated with solutions of known viscosity [14]. Since its](https://figures.academia-assets.com/42576025/figure_003.jpg)
![Fig. 4. FTIR spectra of metakaolinite and selected polymer compositions after curing and drying. Fig. 3(A) shows that in the mixture Na-PSS1 the intensity of the broadened but diagnostic sodium silicate resonances progressively decreases over the first 7 h of the reaction, as the silicate is consumed by the formation of the polymer. The *°Si spectrum remaining after the disappearance of the sodium silicate peaks consists of the original broad signal from the glass tube, with an extended downfield shoulder originating from the solidified polymer. By contrast, the sequence of spectra of mixtures Na- PSS2 and Na- PSS7 [Figs. 3(B) and (C)] shows that although the silicate resonances are broadened by the addition of metakaolinite, suggesting some initial interaction, their intensities remain virtually unchanged up to 15 h after](https://figures.academia-assets.com/42576025/figure_004.jpg)
![Fig. 5. Typical XRD powder diffraction patterns of the starting materials and selected polymer compositions after curing and drying. Asterisks mark the major reflection of quartz (PDF No. 33-1161). The metakaolinite spectrum [Fig. 4(A)] is typical, with broad bands at about 3450 cm‘ and 1650 cm ' from adsorbed atmospheric water, an Si-O stretching vibration at 1088 cm~', an Si-O-Al] vibration at 810 cm~' and an](https://figures.academia-assets.com/42576025/figure_005.jpg)
![Fig. 6. 11.7 T solid-state MAS NMR spectra of the starting material and selected polymer compositions after curing and drying: (A)-(D) *’Al spectra; (E)-(H) *°Si spectra; (I)-(L) *°Na spectra. The ’’Al spectrum of the initial metakaolinite [Fig. 6(A)] is typical of this phase, showing broad overlapping resonances at 52 ppm (tetrahedral), 10 ppm (octahedral) and a resonance at 28 ppm which is often attributed to Al in 5-fold coordination with oxygen [21]. When the metaka- olinite is mixed with the other polymer-forming con- stituents, the Al coordination immediately changes to The kaolinite starting material [Fig. 5(A)] shows the](https://figures.academia-assets.com/42576025/figure_006.jpg)
![Fig. 7. 11.7 T *7Al MAS NMR spectra of several PSS polymer compositions cured at 65°C, plotted on the same intensity scale. The “’Al spectra shown in Fig. 6 have been scaled to the same vertical height, masking considerable differences in the spectral intensities. As shown in Fig. 7, when plotted on the same intensity scale, all the ’’Al spectra are much weaker than that of the well-polymerised PSS1, having integrated intensities ranging from 3.4 to 11% of PSS1, even for samples of the same Al content as PSS1 (Fig. 7). Since the Al is not physically lost from the solid system, having not been detected by solution NMR, the loss of Al signal from the less-well-polymerised samples is probably due to its occurrence in poorly ordered regions in which the signal is broadened beyond detection. Such a phenom- enon particularly affects quadrupolar nuclei such as *’Al, and has been found to occur when a crystalline aluminosilicate such as kaolinite is amorphized by thermal dehydroxylation [22]. The greatly increased *’A1 intensity of sample PSS1 is a reflection of its more ordered polymerised structure.](https://figures.academia-assets.com/42576025/figure_007.jpg)
![Fig. 8. (A) Proposed semi-schematic structure for Na-polysialate polymer. (B) Three-dimensional framework structure based on a suggested model for K-polysialate polymer, after Davidovits [2]. ®, SiQ,(3A1) site; *, SiQ,(2A1) site; 6, SiQ,(1A]) site; @, AlQ,(4Si) site.](https://figures.academia-assets.com/42576025/figure_008.jpg)


![Figure 1. (a) THz absorption spectra from [13]. (b) Comparison study of transmission spectra of RDX using THz-TDS and FTIR (Fourier transform infrared) spectroscopy with data from [13, 14]. The dashed line is RDX from [13]. The other curves are from [14] where the bottom curve is RDX measured by THz-TDS, the solid curve is RDX measured by FTIR, and the top curve is C4 measured by THz-TDS). The sharp features in C4 (THz-TDS) are remnants of water. Note that the absorption features at 0.8, 1.5, 2.0, 2.2 and 3 THz are exhibited in both the datasets. The spectral feature at 1.1 THz is not present in both datasets.](https://figures.academia-assets.com/33672423/figure_001.jpg)
![Figure 2. (a) THz spectra of ammonium nitrate (1 mm thick sample). The dotted line corresponds to measured data of [22]. The dashec line is from [16]. (b) Extended transmission spectra [22] out to 21 THz with nominal sample thickness listed.](https://figures.academia-assets.com/33672423/figure_002.jpg)
![Figure 3. Atmospheric transmission bands in the terahertz range of frequencies (after [8]).](https://figures.academia-assets.com/33672423/figure_003.jpg)





































![Fig. 1. Schematic diagram of generalized energy harvesting process. The history of metamaterials started in 1968 when a theoretical investigation was first proposed by Russian physicist Veselago for electromagnetic waves (EMW) | 13]. More recently, the metamater- ial concept has been extended in parallel to elastic and acoustic waves (EAW) based on the similarity between the EMW and the EAW. Experimental results have revealed that metamaterials can exhibit exotic properties not easily achieved using naturally occur- ring materials, such as negative permittivity, negative permeability, and so on. According to currently published literatures, metamater- ials used for energy harvesting mainly include phononic crystals, acoustic metamaterials, and electromagnetic metamaterials. Acoustic metamaterials are currently in the stage of infancy anc most of the works were explored theoretically. Li and Chan [25 theoretically validated the possibility of the existence of acoustic metamaterials and pointed out that negative effective mass density and bulk modulus could be achieved simultaneously. Zhang [26 presented the first experimental demonstration of focusing ultra- sound waves through a flat acoustic metamaterial lens composed of a planar network of sub-wavelength Helmholtz resonators Fang et al. [27] proposed a new class of acoustic metamaterial which consists of a 1-D array of Helmholtz resonators which exhibits dynamic effective negative modulus. The design, development anc characterization of acoustic metamaterials still bring forth many challenges and opportunities in materials science [24].](https://figures.academia-assets.com/46009463/figure_001.jpg)
![Fig. 2. Classification of materials based on the permittivity and permeability [28] Pendry et al. [29] firstly presented a thin wire component producing negative permittivity and positive permeability and then proposed a split ring resonator (SRR) producing negative perme- ability and positive permittivity [30]. Their innovative works opened up the new research area of metamaterials. Later Smith et al. [31,32] synthesized successfully the first left-handed substance producing negative effective permittivity and permeability, and verified a negative refractive index by practical experiments. Electromagnetic metamaterials have particular properties, such as negative-refractive Vibroacoustic energy harvesting (VAEH) has received extensive attentions over the past decades. Basic conversion mechanisms include piezoelectric, electromagnetic, electrostatic, and magne- tostrictive transduction. However, traditional VAEH methods are often based on linear dynamics. Under this condition, a VAEH device has to be designed to operate optimally at or very close to resonance, so that its electrical output can reach the maximum value. Otherwise, its electrical output will drop dramatically when it is at non-resonance [35,36]. However, it is fatal that the resonant bandwidth of a traditional linear VAEH device is very small.](https://figures.academia-assets.com/46009463/figure_002.jpg)
![Fig. 3. The structure of the phononic crystals-based vibration energy harvester [35].](https://figures.academia-assets.com/46009463/figure_003.jpg)
![Fig. 5. Experimental energy harvesting configurations (a) with and (b) without the PAM configuration [50]. Fig. 4. Acoustic energy harvesting based on phononic crystals [46].](https://figures.academia-assets.com/46009463/figure_004.jpg)
![Chen et al. [42] explored one-dimension phononic piezoelectric cantilever beams to widen the resonant bandwidth of a harvester](https://figures.academia-assets.com/46009463/figure_005.jpg)
![Fig. 8. Acoustic funnel formed by the periodic arrangement of stubs [50]. The second one is to use a 2-D lattice structure with an imperfec- tion, which features a periodic array with an internal defect. The localization of the energy at the imperfection can be exploited for tuned energy harvesting purposes and the fundamental idea is to](https://figures.academia-assets.com/46009463/figure_006.jpg)
![Fig. 6. Comparison of piezoelectric energy harvesters (a) with and (b) without the PAM configuration [50] Carrara et al. [50] studied deeply metamaterial-inspired structures and concepts for elastoacoustic wave energy harvesting and exploited metamaterial-based and metamaterial-inspired electroelastic systems for performance enhancement in piezoelectric power generation. The metamaterial energy harvester (MEH) can enhance harvesting structure-borne elastoacoustic waves. In particular, they proposed](https://figures.academia-assets.com/46009463/figure_007.jpg)
![Fig. 7. 2-D lattice structure made of aluminum stubs with an imperfection [50].](https://figures.academia-assets.com/46009463/figure_008.jpg)
![Fig. 9. The fabricated metamaterial (a) and enhanced WPT system (b) with CMR [75].](https://figures.academia-assets.com/46009463/figure_009.jpg)
![Fig. 1. Effect of impurities on casting fluidity of pure Al cast in sand mold [2]. K.R. Ravi et al. / Journal of Alloys and Compounds xxx (2007) xxx-xxx](https://figures.academia-assets.com/43037105/figure_001.jpg)
![K.R. Ravi et al. / Journal of Alloys and Compounds xxx (2007) xxx-xxx Fig. 2. Spiral fluidity of binary (a) Al-Cu [3], (b) Al-Si [3] and (c) Al-Mg [3] alloys cast in permanent mold.](https://figures.academia-assets.com/43037105/figure_002.jpg)
![Fig. 3. Effect of trace addition on casting fluidity of pure Al cast in sand molc [15].](https://figures.academia-assets.com/43037105/figure_003.jpg)
![Fig. 4. Spiral fluidity of A356 alloy containing 0, 10 and 20 vol.% SiC at different temperatures cast in permanent mold [25]. Cooksey et al. [2] observed that the fluidity versus compo- sition relationship is roughly the inverse of the viscosity versus composition relationship in Al—Si system. Existence of a similar reciprocal relationship between fluidity and viscosity is reported in Fe—Cu-S [28] alloy system. However, in the case of composite slurries, a strict reciprocity is seldom observed between the mea-](https://figures.academia-assets.com/43037105/figure_004.jpg)
![K.R. Ravi et al. / Journal of Alloys and Compounds xxx (2007) xxx-xxx Fig. 5. Variation of spiral length for A356-15 vol.% SiC with varying holding time at (a) 750 °C and (b) 800°C [27]. 2.4. Surface tension and oxide film sured fluidity decrease and the measured or computed viscosity increase as a result of particle addition.](https://figures.academia-assets.com/43037105/figure_005.jpg)
![Fig. 6. Fluidity vs. vol.% of SiC particles in A356 and A357 cast in permanen mold [54].](https://figures.academia-assets.com/43037105/figure_006.jpg)
![Fig. 7. Fluidity vs. particle size of mica in Al-4.5% Cu alloys cast in permanent mold [55]. The morphology of the reinforcement influences the fluid- ity of composite melts because of its effect on the surface area to volume ratio of the dispersed phase. Increasing angularity](https://figures.academia-assets.com/43037105/figure_007.jpg)
![Fig. 8. Variation of spiral fluidity (cast in permanent mold) as a function of specific surface area of ceramic particles [50].](https://figures.academia-assets.com/43037105/figure_008.jpg)
![Fig. 10. Different mode of solidification of alloys: (a) columnar growth and (b) equiaxed growth [58]. Fluidity is generally inversely proportional to the solidifica- tion range [21,57,58]. High fluidity is commonly found to be associated with pure metals and eutectic alloys, wherein solid- ification takes place by the advance of plane interface from the mold wall with the metal flow continuing until the channel is finally choked (Fig. 10(a)). On the other hand, in alloys, constitu- tional undercooling and other phenomena produce independent crystallization in main liquid mass, leading to the presence of free crystals in the liquid, which can arrest the flow and hence reduce the fluidity (Fig. 10(b)). Further, the hindrance caused by crystals with irregular growth surfaces in long freezing range alloys is much greater than that of comparatively smooth crystal- ization interface front of pure metals and eutectic alloys. Thus, fluidity values of pure metals and eutectic alloys are greater than those of alloys solidifying over a temperature range. This is the reason for the wide practical preference for eutectic or near eutectic alloys for foundry purposes, particularly for cast- ing with thin sections. However, a recent study by Han and Xu](https://figures.academia-assets.com/43037105/figure_009.jpg)
![Fig. 9. Fluidity vs. particle shape of SiC in A356 alloys cast in permanent mok [55].](https://figures.academia-assets.com/43037105/figure_010.jpg)
![Fig. 11. Effect of metal mold temperature and pouring temperature on casting fluidity of Al and its alloys on cast iron mold [4].](https://figures.academia-assets.com/43037105/figure_011.jpg)

![Fig. 2. FT-IR spectra of (a) oleylamine (b) Ni nanoparticles and (c) NiO nanoparticles. FT-IR spectroscopy is a useful tool to understand the functional group of any organic molecule (Fig. 2a—c). The presence of oley- lamine group on Ni nanoparticles (Fig. 2b) is indicated by the N-H wagging mode from 650 to 900cm~!; NH2 bending modes at 909, 964 and 993 cm~!; and NH scissor mode at 1568 cm~! [29]. The spectrum shown in Fig. 2b also reveals the characteristic peak of the C-N stretch at 1042 cm~! which suggests that the C-N bonds in amine groups, and therefore oleylamine ligands, remain intact, capping the Ni nanoparticles. The peak at 1468cm~' is associ- ated with the C-H bending mode and the two peaks at 2865 and 2921 cm! represent the C-H stretching modes of the oleylamine carbon chain. The presence of various N-H peaks suggests that amines are bound to the surface of the Ni nanoparticles. Based on the FT-IR data, we deduce the following reaction mechanism. Upon injection of [Ni(aceto)2 | and oleylamine into hot TPP solution, the Ni-O bond is cleaved by the oleylamine group and Ni is subse- quently reduced. The weak peaks at 3435 cm~! has been assigned to the EtOH used in the separation step. The presence of various N-H peaks suggests that amines are bound to the surface of the Ni nanoparticles. There was no evidence of free precursor, nickel 2-](https://figures.academia-assets.com/46989717/figure_003.jpg)



![Figure 8. Scanning electron micrograph of the Delft flux qubit (small loop with three Josephson junctions) and attached SQUID (large loop) [92] (With permission from the Authors).](https://figures.academia-assets.com/40583998/figure_005.jpg)
![Figure 10. Measured probability of state “1” versus microwave excitation frequency w/27 and bias current J for a fixed microwave power for a phase qubit, obtained from Ref. [112]. Dotted vertical line indicate spurious resonators. (With permission from the Authors).](https://figures.academia-assets.com/40583998/figure_008.jpg)

![Figure 1. Scanning electron micrograph of a double quantum dot. [17] (With permission from the Authors).](https://figures.academia-assets.com/40583998/figure_001.jpg)
![where 3 = kpT and the m- appears in the Hamiltonian for the system-bath coupling, m being related to the topology of the dissipative circuitry. However, the most efficient source of dissipation for flux qubits is represented by fluctuations in the external circuit that produce fluctuating magnetic fluxes through the loop. The coupling of flux degrees of freedom of the qubit to the dissipative environmental elements is well described in the graph formalism described in [96]. In the Born-Markov approximation, it can be shown that the Redfield tensor, written in the eigenbasis {|n)} of Hg, is entirely determined by In the two-level approximation, the rates for transitions from the two-level subspace to higher states can be neglected, and Eqs. (117) and (119) simplify and the dynamics of the 2 x 2 density matrix of the system can be cast in the form of Bloch equations for the dynamics of a pseudo spin 1/2. In this framework the relaxation matrix contains just two rates, Ty ' and Ty ! for the decay of the longitudinal and transverse pseudo spin component, respectively. The latter in turn is limited by relaxation time J; and pure dephasing time Ty, 1/T2 = 1/27, + 1/Ty, and the two rates are given by [96]](https://figures.academia-assets.com/40583998/figure_006.jpg)




















![Fig. 1. Calculated phonon-induced spin relaxation time 7 in Al as a function of temperature T. Symbols with error bars are experimental data from [5, 19] and the inset is a larger-scale log-log plot. There is good agreement between the theory and the experiment, but the absence of experimental data at temperatures above 100 K makes the calculation a prediction which is particularly useful for spintronic applications at room temperature.](https://figures.academia-assets.com/46918662/figure_002.jpg)












![Fig. 1. Schematics of generic open quantum dot devices: single aperture throttle and the double aperture square dot 2. Trajectories and streamlines Previous studies have utilized numerical solutions to the steady state Schrédinger equation for square dots (0.3 zm?) using a self-consistent soft wall model [3]. Here we shall use analytical techniques on hard wall models to extract the underlying physics. The Bohm picture projects the Schrédinger equation for U(x, y) = ./p exp[iS/h] into two real equations: the continuity equation and (for the steady state) the energy conservation equation:](https://figures.academia-assets.com/46918662/figure_020.jpg)




![Superlattices and Microstructures, Vol. 27, No. 5/6, 2000 Fig. 5. Numerical calculation for probability density in a square dot using data from [3]](https://figures.academia-assets.com/46918662/figure_025.jpg)



![there is an overall decay with electron temperature, although it is expected to actually be more or less constan below about 1 K, from studies of the zero magnetic field behavior [3]. The magnitude of the relaxation time found here is quite close to the energy-relaxation time determined by a similar process at zero magnetic field While there is certainly some uncertainty in the number of carriers contributing to the resonant peaks (one](https://figures.academia-assets.com/46918662/figure_029.jpg)









![Fig. 1. The main velocity flow processes in a square quantum dot include open orbits which directly traverse the dot, and long meanderin open orbits which thread through clusters of localized vortex flows [1].](https://figures.academia-assets.com/46918662/figure_039.jpg)

































![Superlattices and Microstructures, Vol. 27, No. 5/6, 2000 Fig. 8. Relationship between oxide resistance Rsio, and oxide thickness. Rgi9, was obtained by Eox Tox divided by Ig while Rsion for Ref. [1] was evaluated by Vg(= 1.5 V) divided by Jz. — Calculated by MST, Eox = 5.0 MV cm7!, @, this work MOSFET, Eox = 5.0 MV cm7!; a, this work MOS diode, Eox = 5.0 MV cm7!; 0, MOS diode, Vz = 1.5 V [1]; A, MOS diode, Eox = 5.0MV cm! [2].](https://figures.academia-assets.com/46918662/figure_078.jpg)


















![Fig. 1. Schematic views of the lowest conduction bands of Si and SiOz, projected on an axis through ky = 0 that points in the [010] (or, equivalently, in the [001]) direction. The SiOz bands are shifted relative to the Si bands by the conduction band offset Ecgg. A, Effective-mass picture B, tight-binding picture for the 2 x 2 structure studied here: the bulk Si bands are folded in the 2 x 2 Brillouin zone; the cross and circle indicate regions where electrons from different valleys couple. C, is the same as B, but outfolded back in a 1x 1 cell.](https://figures.academia-assets.com/46918662/figure_100.jpg)







![Fig. 3. A, J-V characteristics for MOSFET structure using the 2D Poisson solver. B, Potential profile using the 3D hybrid CA/multigri algorithm for Vg = 2.88 V and Vg = 2.0 V. When used in this hybrid mode, the simulator can adaptively update the transition/scattering tables to account for changes in the location of high scattering regions. aa — — _— In the present work, acoustic phonons, nonpolar optical phonons and ionized impurity scattering are in- cluded. The models used are essentially identical to those used in Fischetti and Laux [4], in order to compare the results for the full-band CA (see Fig. 1). Impact ionization is also included with a separate algorithm due to the multi-particle nature of this mechanism. The energy-dispersion relation and the phonon spectra are calculated across the entire Brillouin zone using an inhomogeneous grid. Due to symmetry, only values in the irreducible wedge of the first Brillouin zone actually need to be determined and stored. The band structure is calculated using the nonlocal empirical pseudopotential method (EPM) [5] including spin-orbit interaction, and the phonon dispersion is calculated using an empirical shell model [6]. Both electrons and holes are simulated.](https://figures.academia-assets.com/46918662/figure_108.jpg)
![Fig. 1. The calculated resistivities for various electron densities, ns = 1.03, 1.08, 1.19, 1.31 x 10!! em-2 (top to bottom) as a function of T for the Si-12 sample of Ref. [1], using the critical density np = 10!! cm7?. In the inset we show the analytic zero-temperature conductivity as a function of density 1. Points represent extrapolated o(7 — 0) from Si-12 sample of Ref. [1].](https://figures.academia-assets.com/46918662/figure_109.jpg)
![Fig. 1. Ratio of energy relaxation rates to bulk values vs. temperature for a semiconductor bounded by a vacuum (a metal film). The distance zg from the crystal surface to the center of a QW equals 3d/2, where d is the width of the well. Sheet electron concentrations ns are: 1-10!! em=?; 2, 4, 5-2.2 x 10!! em7?; 3-3 x 10!! cm=?; well widths, d: 1, 2, 3-50 A, 4-40 A, 5-100 A. The curves marked by a circle in the upper part of the figure correspond to a semiconductor in contact with a metal film. The transition probability due to the interaction with phonons is calculated within the fermi golden rule approximation. Further derivation of the total relaxation rate may be carried out in analogy to that for DP scattering [3]; the procedure yields the following final form](https://figures.academia-assets.com/46918662/figure_110.jpg)



![Fig. 2. Evolution of the sheet carrier concentration (full line) and of the electron mobility (dashed line) measured by the Hall effect on hydrogenated n-type Si-doped GaAs epilayer versus the electron number dose for various electron injection energies : 10 (Ml), 20 (4) and 30 keV (@). scanning electronic microscope (SEM) or an electron lithography system. Such a method has already been used for acceptors reactivation in Mg-doped GaN [6]. To test this possibility in the case of Si- doped GaAs, experiments have been carried out on 0.35 wm thick Si-doped epilayers grown by molecular-beam epitaxy. From the Hall measurement, sheet electron concentration N, = 1.4 x 10!4 cm™~? and free carrier mobility pun = 1690 cm? V s~! have been obtained. The layers are then exposed to a RF plasma under the following conditions: temperature of 190°C, hydrogen pressure of 1 mbar, RF power of 0.16 W cm~? for 8 h. After plasma exposure, the samples are characterized for Ns = 4.6 x 10!? cm? and un = 3550 cm? Vs7!. These results can be explained by the neutralization of ionized donors, and the increase of mobility is due to he decrease of ionized impurity scatterings. Then, we have exposed the whole clover surface to the focused electron beam of a SEM with different electron injection energies: 10, 20 and 30 keV. The obtained results for an increasing incident electron number are presented in Fig. 2.](https://figures.academia-assets.com/46918662/figure_114.jpg)












![Measurements in nonzero magnetic fields The following gives a brief account of the results obtained when a magnetic field is applied parallel or perpendicular to the direction of the tunneling current. Both types of experiment give additional evidence that the structure observed in the dI /dV} curves, when the central gate is negatively biased, in indeed due to tunneling between 1D states. Figure 6 shows how the peak positions of the 1D-1D tunneling structure in Fig. 2 evolve with a magnetic field applied parallel to the tunnel current. The central gate voltage in this case was Vcg = —0.8 V. An example of typical d//dVp trace at B = 5 T is shown in Fig. 3A. As can be seen in this figure, there is no significant change in the qualitative features of the respective tunneling characteristics. Figure 6 shows moreover that even in the peak positions no significant change occurs as long as the magnetic field strength is smaller than 3 T. This is exactly what one expects, if the tunneling indeed occurs between 1D levels. A magnetic field perpendicular to the sample surface leads to a B-dependent subband spacing according to ha = (hwo)? + (hw-)2, where w, denotes the cyclotron frequency and wo is the spacing of the 1D sub- bands without magnetic field. At low magnetic fields the electrostatic confinement (characterized by wo) con- sequently dominates the additional confinement introduced by the magnetic field, whereas at high B-values the opposite is true. As already discussed by Mori et al. [11, 14], in the first case tunneling occurs between 1D states of equal parity, in the second case mainly between magnetoelectric hybrid (Landau) levels of identical LL index. There should therefore occur a crossover between the two cases when the magnetic confinement begins to dominate over the electrostatic one. One expects additional peaks beyond this crossover, since tun- neling is now also allowed between magnetoelectric hybrid levels of the same index. As seen in Fig. 6, there is indeed some evidence of such a crossover between 2.5 and 3.5 T. At lower magnetic fields the peak po-](https://figures.academia-assets.com/46918662/figure_126.jpg)

![the behaviour of the gross structure of the tunneling characteristics, which according to the model of Mori et al. [11] should indeed give almost identical results for both magnetic field directions. Summary The above considerations demonstrate that the side-gate technique indeed gives a simple and flexible possibility to implement both a selective depletion scheme and a lateral confinement which is very effectively tuned by the voltage applied to the central gate. The tuning range of the 1D sublevel spacing has been found to lie between effectively 0 and about 6 meV, allowing the study of 2D-2D and 1D-1D tunneling processes on one single device. The above selective depletion scheme can be applied to a variety of mesa geometries and is not restricted to two-terminal configurations. The only essential prerequite for the introduced side-gate technique is to have sufficiently different carrier densities in the two barrier-separated electron gases. Our results also show that the use of gate-tunable etched quantum wire structures allows us to obtain 1D subband energies, which are indeed in a range interesting for the application of quantum wires as detecting devices](https://figures.academia-assets.com/46918662/figure_128.jpg)


![Fig. 3. Waterfall plot of conductance G versus Vp and Vg shows uniform quantized conductance steps for regime (iv), where only one 1D wire is present. A complex interference of the steps is evident in regime (iii), where both 1D wires are occupied. Fig. 2. Sample resistance versus Vp with Vg = 0. Inset at bottom shows transition from regime (i) to (ii) at Vy = —0.3 V. The transition from regimes (ii) to (iii) can be seen at Vp = —0.7 V while a distinct increase in slope at Vy = —2.6 V marks the transition from (iii) to (iv). plot. However, when both wires are occupied (regime iii), quantized steps are again present, but form a complicated interference pattern. By tracking the position of individual conductance steps as a function of both Vy and Vp, each step can be assigned to one quantum wire or the other. Clearly, each QPC width—and thus the number of occupied subbands—can be independently controlled by the action of Vp and Vz. LM ERM RMR: a EL RE N,N ee , ae e ee eeeNNee meee: Rk emer: eee We now turn to the behavior of the conductance under an in-plane magnetic field B applied perpendicular to the direction of current flow. Figure 4 shows a contour plot of the logarithmic derivative of the resistance d[In(R)]/dVz, as a function of Vp and Vg. The different regimes are again readily identifiable. Insets (a)—(e) show G versus B taken at several different values of Vr and Vg. Inset (a) was taken at Vp = —0.25 V and Vg = 0.0 V. The familiar 2D-2D anticrossing features, a conductance peak followed by a shallow dip, are centered about B = 6.5 T. This is consistent with the sample being in regime (i) [6].](https://figures.academia-assets.com/46918662/figure_131.jpg)
![Fig. 4. Contour plot of the logarithmic derivative of the resistance A[In(R)]/0Vy. The different regimes are readily identifiable. Insets (a)-(e) are plots of G versus B taken at the indicated values of Vp and Vg. Here, where the in-plane B is perpendicular to the current direction, a broad conductance dip develops in regime (iii).](https://figures.academia-assets.com/46918662/figure_132.jpg)
![Fig. 5. Contour plot of the logarithmic derivative of the resistance d[In(R)]/8Vy, where again insets (a)-(e) are plots of G versus B taken at the indicated values of Vr and Vg. Here the in-plane B is oriented parallel to the current direction, and no broad conductance dip is seen to develop.](https://figures.academia-assets.com/46918662/figure_133.jpg)


![Fig. 2. Absorption spectrum of the Al-clad InAs structure. A and B show the intersubband absorption of the same sample before (A) InAs quantum states are confined by AlSb barriers and after (B), processing the sample to the Al-InAs structure. and a well-width fluctuation induced by the process and/or by reaction of Al with InAs [6]. The data suggest that despite the expected transmissivity of the Al-InAs interface, the electrons are strongly reflected either by band structure discontinuity or formation of a AlAs barrier. In Fig. 3, we show the absorption of a W—InAs quantum well compared with the barrier bound system. The process followed the Ai-InAs quantum well shown in Fig. 2. We found that W—InAs exhibits intersubband absorption, shifted toward higher energy and broadened, showing that the W-InAs interface is also reflective in a way somewhat similarly to Al-InAs. The amount of peak shift, 26.1 meV, is of the same order as the shift in Al-InAs. However, W—InAs shows an anomalous absorption in the lower energy side of the original intersubband peak which is not observed in the Al-InAs structure. The width increase Aw = 67.1 meV is more than factor of 2 of A,4;. This anomalous absorption cannot be accounted for by well-width fluctuation. Similar anomalous low-frequency absorption is also observed in structures using Pt, Ag, In, Au, Nb, and Ti. Nearly same peak shift of both Al-InAs and W-InAs indicates that the effect of the etching and Ar plasm](https://figures.academia-assets.com/46918662/figure_136.jpg)




![Fig. 3. Self-assembled Au dots on adjacent oxide and Cr regions. The direct comparison can isolate the thermal effects and offe information on formation energy and effects of surface roughness. Fig. 4. Self-assembled Au dots on smooth oxide with E-beam-prescribed Cr arrays. This hybrid process can be used to characterize self-assembly forces since Cr has much smaller surface mobility than Au and serves as place-holders. functional density is only comparable to CMOS, then the SA process can only enhance structural stability. This leaves a small window of functional density of the SA structures if interface with CMOS circuitry is necessary. The number of zones of nano-crystals floating gates associated with electronic functions in the proposed nano-crystal EEPROM cell is hence quite limited, unless direct information access can be provided from the third dimension as in the tera-bit storage case [4]. Another possible way to surpass the Rent’s limit is by considering that the electronic functions are very different in nature than logic circuits, as in the case of electronic synapse [1]. This, however, implies a complete change in processing architecture. If only four](https://figures.academia-assets.com/46918662/figure_141.jpg)


![Fig. 8. Demonstration of process flow for the nano-crystal floating gate device. Notice that this flow is for illustration purposes only. The geometry is not drawn to scale. ure 5 shows the simulated channel carrier concentration in a 50 nm split-gate MOSFET using a conventional drift-diffusion model, where DIBL asymmetry is indeed significant. Programming of each individual zone can be achieved through hot-carrier injection with the bias condition shown in Fig. 6. Erasing all four nodes can be achieved by tunneling through the control gate. This is similar to the popular FLASH operations [6].](https://figures.academia-assets.com/46918662/figure_144.jpg)














































![obtained using the FDFD method [2]. An increase in the length of the bond wire results in a larger overall S\1. At higher frequencies, the structure resonates thereby forcing $1; to zero. However, compared with the microstrip interconnection through an air bridge, which is shown in Fig. 2, the bond wire creates higher reflections. For example, at a frequency of 4 GHz, a bond wire with length 3.17 mm and height 0.2 mm causes more than 50% reflections. On the contrary, the microstrip interconnection through an air bridge, at the same frequency, causes only 25% reflections. The electrical performance of an MMIC is drastically altered when mounted into a package such as the eight-lead small outline integrated circuit (SOIC-8) surface-mount plastic package shown in Fig. 4. Plastic packages have been used for years up to a frequency of about 2.5 GHz. It becomes extremely difficult to utilize these packages for higher frequencies mainly because of poor grounding of the paddle and package resonances. First, the MMIC shown in Fig. 5 is analysed in the absence of the package. This circuit represents a basic through-connection with a stub. When placed into the package, the circuit itself is elevated 0.1 mm above the ground and embedded into a dielectric medium with dielectric constant ¢, = 4. The same MMIC structure, mounted into the SOIC-8 surface-mount package, was analysed by Jackson [3] using the method](https://figures.academia-assets.com/46918662/figure_192.jpg)




![Fig. 2. A, /—Vgq characteristics at 4.2 K for gate voltage Vg ranging from —1 to —6 V with an increment of 20 mV. The curves are offset for clarity. B, Gray-scale plot of the differential conductance. the energy level spacing AE = 2.3 meV, which happens to be the similar value to Ec, from the measurements . of Coulomb blockade oscillation for large source—drain bias voltages. The charging energy corresponds to a temperature of about 100 K. By narrowing the distance between the two contacts, we may be able to achieve the Coulomb blockade effect at room temperature in the future. Fae MSE LEAN Te ER AATISAR AMA NRTA SE LT ENe Re AT SEATHIGGEE IAT AEP OaNR ORME ESP A SAMNT GN SERELE he Tae” SORRER NSS SAMI se sie nconewe octenabet dae em In Fig. 3, the effect of the microwave irradiation on J—Vsqg characteristics is shown. The data were taken at the lowest temperature with the microwave power changing from —40 dBm to —12 dBm, while the lowest one corresponds to the curve without irradiation. We should note that the applied microwave power was kept small such that the temperature would not change during the measurement. Without microwave irradiation, the curve shows the Coulomb gap and structures due to the excited state of the OD quantum state. As the microwave power is increased, the curve becomes smooth with less structure. The differential conductance, which is calculated from the J—~Vsq data and shown in the inset of the figure, indicates that the curve become less structured as the microwave power is increased. We have made measurements at different frequencies and at 4.2 K, and observed the similar result. These experimental observations suggest the classical coupling mechanism of high-frequency radiation to the dot. The high-frequency field couples to the source—drain volt- age as an ac source in addition to the dc bias voltage. The measured dc current under microwave irradiation is the time-averaged current over the modulating voltage around the fixed dc bias voltage. This may explain the observed J—Vgq characteristics under microwave irradiation. At the moment, we do not fully understand the reason of the classical coupling even through hf for 20 GHz (~1 K) is larger than kT (~0.25 K) [8-10]. Since special care was not paid to the connection between the coaxial line and the sample gate, the electro- magnetic field around the dot could be very much complicated. The microwave signal may couple to various electrodes with macroscopic dimensions, resulting in the effective modulation of Vgq.](https://figures.academia-assets.com/46918662/figure_197.jpg)
![Fig. 1. A schematic diagram of the nanocontact structure utilizing a 4 nm diameter Au cluster, a self-assembled monolayer of xyly dithiol and a GaAs heterostructure with a chemically stable surface layer. Conjugated organic molecules that are difunctional such as aryl dithiols can provide mechanical link- ing/tethering between a cluster and another surface (a cluster or a semiconductor/metal surface) as well as 1 path for electronic conduction between the respective conductors. The specific molecule used for linking the metal nanoclusters to the semiconductor surface in this study is xyly! dithiol (HS-CH2—C~gH4-CH2-SH) which will be referred to as XYL for brevity. This molecule has a length of approximately 1 nm and has thiol (-SH) end groups on each end. These thiol groups can chemically bond to the GaAs surface and to the gold nanoclusters. A self-assembled monolayer (SAM) of XYL is grown on the GaAs surface; given the size of the molecule and the expected packing density, it is believed that a number of XYL molecules (approx- imately 30) are packed within the area of a facet on a 4 nm diameter Au cluster. The interface between a nanocluster and the GaAs surface therefore consists of a small bundle of XYL molecules. XYL is one of aclass of conjugated organic molecules that have been studied as molecular conductors [7— 9]. Such experimental studies typically involve the formation of a self-assembled monolayer (SAM) of the desired molecule on a relatively flat Au surface, with a top contact formed either by metal evaporation, deposition of a metal nanocluster, or by a scanning probe tip (e.g. a scanning tunneling microscope (STM) ip). Theoretical descriptions of the current-voltage relationships have been developed based on the scattering heory of transport. With proper treatment of the Fermi level position in the molecule, of the coupling strength o the contacts and of the capacitive division of the applied voltage, the low-field resistances and current— voltage characteristics for the various experimental reports can be adequately described by this modeling approach [7, 9]. If strong bonding (i.e. strong electronic coupling) to the metallic contacts is realized, vertical rransport through a SAM of a short molecule such as XYL should have a specific resistance on the order of x 1078 Q cm?. el](https://figures.academia-assets.com/46918662/figure_199.jpg)
![with the corresponding curves for the measurement over the XYL coated surface (without cluster). The curves shown in Fig. 2 are taken at relatively low set-point currents, corresponding to relatively large tip-to- sample distances. In order to determine the resistance of the nanocontact, i.e. the resistance between the Au nanocluster and the doped layers in the semiconductor structure, it is necessary to reduce the tip-to-cluster distance, and thereby the tip-to-cluster resistance. This has been accomplished by monitoring the current (J) at constant voltage as the tip height (z) is decreased with respect to the height at the low-current set-point. For a structure in which the LTG:GaAs layer is undoped (n-type), the measured / (z) relationship saturates as the tip is brought closer to the cluster. In the saturation regime, the overall resistance should be dominated by the cluster-to-substrate resistance, so the desired nanocontact resistance can be determined from the ratio of the applied voltage to the the saturation current [15]. For this case, the specific contact resistance is approximately 1 x 107° Q cm? and the maximum current density is approximately 1 x 10° A cm~* [15]. For a structure in which the LTG:GaAs layer is heavily doped with Be, as is the case in Fig. 2, values of p, of approximately 1 x 10-7 Q cm? and the maximum current density of approximately 1 x 10’ A cm~? are obtained. Both of these values are comparable to the values achieved in high-quality large-area ohmic contacts to n-type GaAs [16]. In this case, the measurement system limits the minimum , which can be resolved, so the contact resistance may be somewhat lower than this value. Thus, the measured specific contact resistances for the best nanocontact structures are somewhat better than those achieved in the large-area contact studies, indicating that high-performance nanocontacts can be formed to GaAs device layers using this nonalloyed ohmic contact approach.](https://figures.academia-assets.com/46918662/figure_200.jpg)

![Fig. 4. Calculated conduction band profile for ohmic contact structure (metal/GaAs) with a 3 nm thick LTG:GaAs layer on the surface. The curve is for a structure with a barrier height of 0.5 eV, a doping density in the nt-GaAs layer of 1 x 1029 cm73 and a temperature of 300 K. Also shown is the parabolic conduction band profile for an equivalent uniformly doped Schottky barrier, assuming complete ionization. versus temperature. Based on comparisons between the experimental results and the predictions, it appears that the surface barrier heights are well below mid-gap values and that activated donor densities above the bulk amphoteric limit have been achieved in the space charge region [17]. It is typically not possible to achieve either of these effects in ex situ contacts to n-type GaAs, due to the surface Fermi level pinning associated with rapid surface oxidation and the bulk amphoteric doping limit in stoichiometric layers. The achievement of both effects in this structure is attributed to the passivating effects of the thin LTG:GaAs layer and to the associated Fermi level control. The ability to achieve an activated donor density within the surface space-charge region which is higher than the bulk amphoteric limit has been explained in terms of the control of Fermi level during growth and the passivation effects of the LTG:GaAs layer [10]. It should be noted that the semiconductor heterostructure is typically exposed to air for prolonged periods before contact processing, so a portion of the LTG:GaAs layer does oxidize during this storage period. Since this oxidation appears to cause mid-gap surface Fermi level pinning even in LTG:GaAs following prolonged air exposure [18], the surface oxide must be stripped shortly before contact metallization. It is believed that the oxide strip restores the surface Fermi level to an unpinned state, with a re-oxidation time constant of hours.](https://figures.academia-assets.com/46918662/figure_202.jpg)




![domain with misaligned magnetization under the magnetic field survives at higher temperature than the aligned magnetization. 3.2. Single-walled carbon nanotube For the SWNTs, the transport is more complicated. In the SWNT two-terminal device with a metal contact, single-electron tunneling was observed [8, 9].](https://figures.academia-assets.com/46918662/figure_207.jpg)

![Irradiation of InP-asbestos with the pump beam in resonance with the exciton band results in a high density of electron-hole pairs in QWRs. Some of them tunnel from QWRs to template defects and saturates defects sites at the interface. This effect is equivalent to transferring a negative charge on these defects. The remaining electrons relax radiatively within a few nanoseconds in a QWR after finishing the pump pulse [7]. In contrast, all excitations in the template are frozen by the potential barrier. This assumption correlates with the observation of long-living changes of PL spectra of the pumped sample, moreover the pump memory is erasable by exposing the sample to light of frequency below the absorption edge of InP](https://figures.academia-assets.com/46918662/figure_209.jpg)























![To solve this problem, we prepare a multiple-valued Hopfield network such that the output u; of each neuron represents each problem variable x;; we prepare neurons with the staircase transfer function illustrated in Fig. 2 and represent problem variables x; by x; = u;/a. The connection weights required for mapping the problem are given in Fig. 2. In problem solving, we set the network in an initial state (any state will do), then allow it to change its state without restraint. After some transition time the network converges to a final state. If convergence has been successful, the solution to the problem is obtained from the final state of the network (we will not discuss the local-minimum effect here). 3. Constructing a multiple-valued neuron using single-electron circuits The single-electron circuit is an electronic circuit consisting of tunnel junctions and capacitors that is de- signed for manipulating electronic functions by controlling the transport of individual electrons. The internal state of the circuit is determined by the configuration of its electrons (i.e. the pattern in which the excess elec- trons are distributed among the nodes of the circuit). The circuit changes its electron configuration through electron tunnelings in response to the input and, thereby, changes its output voltage as a function of inputs. etree, a a SO ~ Our purpose is to construct a single-electron neuron circuit that changes the charge on its output node (therefore its output voltage) according to a staircase function of the input voltage. For this purpose, we take Tucker’s single-electron inverter and modify its circuit parameters to create a staircase transfer function (for the details of Tucker’s original circuit, see [1]). The circuit we use for the neuron devices is illustrated in Fig. 3 together with a sample set of device parameters. The corresponding transfer characteristic are illustrated in Fig. 4. The number of steps in the transfer characteristic can be controlled by designing the circuit parameters.](https://figures.academia-assets.com/46918662/figure_233.jpg)










![Table 1: Bandstructure model parameters. All energies are in units of eV and the lattice constant is in units of nm. that the sp3s* nearest-neighbor model pathologically predicts an infinite transverse mass at the X-point [2, 3]. With the limitations of the sp3s* model in mind it must be emphasized that early parametrizations [1] pro- vided more global band structure fits for bands which can be probed by optical measurements. The compli- cation in the fitting process of the 15 orbital interaction energies to measurable quantities has led to the use of the seminal Vogl [1] parameters in areas in which they were not intended. For example, quantitative electron transport simulations in high-performance resonant tunneling diodes [4] require the proper representation of relative band energies as well as band curvature of the conduction and valence bands, even for a purely electronic device (no hole transport).](https://figures.academia-assets.com/46918662/table_004.jpg)





















![Fig. 2. Water contact angle of different time plasma-treated PP (left) and PET (right) fibres versus storage time at ambient temperature [285]](https://figures.academia-assets.com/39291733/figure_002.jpg)

![Fig. 4. Water-repellent properties of cotton fabrics treated with DEAEPN (a) before and (b) after grafting and polymerisation of AC8, washing, and drying at 373 K [287].](https://figures.academia-assets.com/39291733/figure_004.jpg)
![Fig. 5. Effect of microwave plasma cleaning with different gas mixtures and varying pressure [288]. Cai et al. [176] applied air/He and air/O,/He atmospheric plasma treatments to desize PVA on cotton. The air/O,/He reatment showed to have a greater effect on PVA than the air/He plasma. Both plasma treatments did not only serve to remove some PVA size, but also to significantly facilitate PVA removal by subsequent washing. The authors attributed this effect to the enhanced swelling, dissolving and dispersing of PVA. The ensile strengths of the fabrics and yarns were not statistically significantly affected by the plasma treatment. The same authors also applied both treatments for desizing PVA on rayon (viscose) fabrics [177]. Both treatments were able to remove some of the PVA on the rayon and increase PVA solubility in cold water, resulting in a higher weight loss in cold washing. The effect of he atmospheric pressure plasmas became greater as the treat- A comparative study between plasma and wet chemical cleaning of synthetic fibres was done by Keller et al. [182]. In this work, different cleaning methods were compared in order to remove sizes on PET multifilament fibres, namely chemical](https://figures.academia-assets.com/39291733/figure_005.jpg)
![Fig. 6. Characteristic survival curve for micro-organisms on a PP sample containing an initial loading of 6x 10° Z. coli K12 cells treated by an OAUGDP [289].](https://figures.academia-assets.com/39291733/figure_006.jpg)
![Fig. 7. 3D views of AFM images of PET textile surface. (a) Untreated surface; (b) 60 s treated surface; (c) 120 s treated surface [290]. Plasma treatments can improve properties such as (tear) strength, elongation, stiffness, etc. A number of studies were published by Thorsen from the second half of the 1960s onwards on improved frictional properties of fibres by AC corona treatment at atmospheric pressure [205—207]. The tensile strength of wool, mohair and cotton yarns increases with 12—26%, 31% and 28% respectively, even after treatment as short as | s. This frictionising can further lead to improved mohair carding and to an increase in wool fibre spinning rate into yarns and improved cotton spinnability. McCord et al. demonstrated the effect of gas composition of the plasma on tensile strength of nylon [208]. They had a slight decrease in nylon fabric tensile strength after treatment in He for 3 min, while there was no significant change in tensile strength of the nylon fabric treated with He—O, after exposure times of up to 8 min. Belin et al. [209] showed that cotton sliver tenacity was improved for a single corona passage and even more for three consecutive passes. They also observed an improved wettability and dye adsorption [210]. In the former case, increased felting The treatment of PET fabrics in a SiCl, plasma has been done to improve their comfort-related mechanical and surface properties [30]. The primary effect of the plasma treatment was on the surface roughness, in good accordance with atomic force microscopy (AFM) roughness data. A similar AFM study was](https://figures.academia-assets.com/39291733/figure_007.jpg)
![Wettability of wool, polyester, and polyamide 6 fabrics treated with corona discharge [37]](https://figures.academia-assets.com/39291733/table_001.jpg)
![Contact angle of silk and cotton fabrics treated by C3F¢ plasma for various treatment times [150] Table 2](https://figures.academia-assets.com/39291733/table_002.jpg)
![Change in whiteness of wool of different fineness treated with a gliding discharge in different environments [199]](https://figures.academia-assets.com/39291733/table_003.jpg)
![Wettability and antistatic ability of the untreated and plasma-treated samples [243]](https://figures.academia-assets.com/39291733/table_004.jpg)
![Values of the DFE for (non) plasma-treated woollen fibres [248] Table 5](https://figures.academia-assets.com/39291733/table_005.jpg)


![Fig. 3. PtRu[111]/C[0015] peak height ratio vs. thermal treatment temperature. took place starting from 300°C, and the intensity of PtRu[111] reflexion increased, owing to the increase of the crystallinity, up to around 450°C. Then the PtRu[111] peak](https://figures.academia-assets.com/49092773/figure_003.jpg)
![Fig. 4. Dependence of PtRu d-spacing for [220] (a) and [311] {b) reflexions on thermal treatment temperature (d-spacing error+0.001 A). The dependence of d-spacing of PtRu[220] and PtRu[311] reflexions on thermal treatment temperature is shown in Fig. 4a,b. The d-spacing of both reflexions decreased with increasing annealing temperature. This reduction in d-spacing corresponds to a reduction of the attice parameter, resulting from the replacement of the platinum atoms on the lattice points of the f.c.c. crystal structure by the smaller ruthenium atoms. From d-spacing values of [220] and [311] reflexions, we have calculated the lattice parameter of PtRu alloys. Fig. 5 shows the dependence of PtRu lattice parameter on thermal treatment temperature. Lattice constant values were lower than that of pure platinum supported on KJB (upper dashed line), and higher than that of unsupported PtRu alloy with Pt:Ru atomic ratio 1:1(lower dashed line). The lattice parameter decreased with increasing temperature. The lowest value of the lattice parameter was similar to the value of the lattice](https://figures.academia-assets.com/49092773/figure_004.jpg)
![Fig. 5. PtRu lattice constant vs. thermal treatment temperature. Lattice parameter error+0.0025 A. (@) PtRu/C (KJB) with Pt:Ru atomic ratio 1:1; (O) PtRu/C (V) with Pt:Ru 1:3; (upper dashed line) pure Pt on KJB carbon thermal treated at 400°C; (lower dashed line) unsupported PtRu with Pt:Ru 1:1 [6].](https://figures.academia-assets.com/49092773/figure_005.jpg)





















![Friction coeffecient and wear rate of different types of DLC coating in different environmental condition’? uv refers to coeffecient of friction K refers to wear rate [x10~-°mm3(N m)/] Me refers to metal, such as W,Ti, Mo, Fe, V... X refers to nonmetal, such as Si, O, N, F, B... TABLE 1](https://figures.academia-assets.com/46430163/table_002.jpg)


